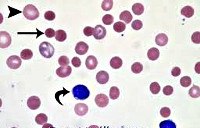

Другие названия и синонимы
Methemoglobinemia.
МКБ-10 коды
- МКБ-10
- D74 Метгемоглобинемия
|
|
Описание
Метгемоглобинемия. Состояние, характеризующееся повышенным содержанием метгемоглобина (окисленного гемоглобина) в крови и тканевой гипоксией. Развитие метгемоглобинемии сопровождается акроцианозом, слабостью, головными болями, головокружением, сердцебиением, одышкой при нагрузке. Характерным признаком метгемоглобинемии служит коричнево-шоколадный цвет крови. Для подтверждения диагноза проводится оценка симптоматики, лабораторные исследования и тесты. При тяжелой степени метгемоглобинемии показана кислородотерапия, введение аскорбиновой кислоты, раствора метиленового синего, в ряде случаев - обменная гемотрансфузия.
Дополнительные факты
Метгемоглобинемия - увеличение уровня гемоглобина, содержащего окисленное железо (метгемоглобин - MtHb), в эритроцитах крови. Метгемоглобин относится к так называемым дисгемоглобинам - дериватам гемоглобина, не способным транспортировать кислород. В обычных условиях в крови присутствует небольшое количество метгемоглобина - не более 1% от общего содержания Hb. При метгемоглобинемии эндогенные механизмы оказываются не способными регулировать концентрацию дисгемоглобина, в результате чего страдает кислородно-транспортная функция эритроцитов. В гематологии метгемоглобинемии подразделяются на наследственные и приобретенные. Первые из них распространены среди коренного населения Аляски, Гренландии, Якутии; частота развития приобретенных метгемоглобинемий неизвестна.
Причины
В процессе метаболических превращений в крови здоровых людей в очень небольших количествах образуются дисгемоглобины: карбоксигемоглобин, сульфгемоглобин, метгемоглобин (0,1-1 %). Вместе с тем, в эритроцитах содержится ряд факторов, которые поддерживают долю фракции метгемоглобина на уровне, не превышающем 1,0-1,5% от общего Hb. В частности, в реакции восстановления метгемоглобина в гемоглобин участвует фермент метгемоглобин-редуктаза. В отличие от оксигемоглобина (НbО2), содержащего восстановленное железо (Fe++), в метгемоглобине содержится окисленное железо (Fe+++), не способное переносить кислород. Поэтому при метгемоглобинемии, прежде всего, страдает кислородно-транспортная функция крови, следствием которой служит тканевая гипоксия.
Наследственные формы метгемоглобинемии представлены либо ферментопатиями (врожденной низкой активностью или отсутствием фермента метгемоглобин-редуктазы), либо М-гемоглобинопатиями (синтезом аномальных белков, содержащих окисленное железо).
В структуре приобретенных (вторичных) метгемоглобинемий выделяют токсические экзогенные и токсические эндогенные формы. Метгемоглобинемии экзогенного происхождения могут быть связаны с передозировкой лекарственных средств (сульфаниламидов, нитритов, викасола, противомалярийных препаратов, лидокаина, новокаина и тд ) или отравлением химическими агентами (анилиновыми красителями, нитратом серебра, тринитротолуолом, хлорбензолом, питьевой водой и пищевыми продуктами с высоким содержанием нитратов и тд ).
Повышенный уровень MtHb в крови наблюдается у недоношенных и доношенных новорожденных, что связано с низкой активностью фермента метгемоглобин-редуктазы и окислительным стрессом в родах. Однако даже при тяжелой гипоксии и желтухе новорожденных подъем MtHb не столь выражен и клинически значим, чтобы послужить причиной метгемоглобинемии. Однако при диарее, бактериальных и вирусных энтероколитах, в условиях метаболического ацидоза у детей первого года жизни может легко развиться приобретенная эндогенная метгемоглобинемия.
О смешанной форме патологии говорят в том случае, если метгемоглобинемия развивается под воздействием экзогенных факторов у здоровых лиц, являющихся гетерозиготными носителями генов наследственной формы заболевания.
Наследственные формы метгемоглобинемии представлены либо ферментопатиями (врожденной низкой активностью или отсутствием фермента метгемоглобин-редуктазы), либо М-гемоглобинопатиями (синтезом аномальных белков, содержащих окисленное железо).
В структуре приобретенных (вторичных) метгемоглобинемий выделяют токсические экзогенные и токсические эндогенные формы. Метгемоглобинемии экзогенного происхождения могут быть связаны с передозировкой лекарственных средств (сульфаниламидов, нитритов, викасола, противомалярийных препаратов, лидокаина, новокаина и тд ) или отравлением химическими агентами (анилиновыми красителями, нитратом серебра, тринитротолуолом, хлорбензолом, питьевой водой и пищевыми продуктами с высоким содержанием нитратов и тд ).
Повышенный уровень MtHb в крови наблюдается у недоношенных и доношенных новорожденных, что связано с низкой активностью фермента метгемоглобин-редуктазы и окислительным стрессом в родах. Однако даже при тяжелой гипоксии и желтухе новорожденных подъем MtHb не столь выражен и клинически значим, чтобы послужить причиной метгемоглобинемии. Однако при диарее, бактериальных и вирусных энтероколитах, в условиях метаболического ацидоза у детей первого года жизни может легко развиться приобретенная эндогенная метгемоглобинемия.
О смешанной форме патологии говорят в том случае, если метгемоглобинемия развивается под воздействием экзогенных факторов у здоровых лиц, являющихся гетерозиготными носителями генов наследственной формы заболевания.
Клиническая картина
Признаки наследственной метгемоглобинемии становятся заметны в период новорожденности. На коже и видимых слизистых ребенка (в области губ, носогубного треугольника, мочек ушей, ногтевого ложа) заметен цианоз. Кроме наследственной метгемоглобинемии, у детей часто выявляются другие врожденные аномалии - изменения конфигурации черепа, недоразвитие верхних конечностей, атрезия влагалища, талассемия и пр. Нередко дети отстают в психомоторном развитии.
В зависимости от уровня фракции MtHb, выраженность проявлений врожденной и приобретенной метгемоглобинемии может значительно варьировать.
При концентрации MtHb в крови:
•.
• 3-15% - кожные покровы приобретают сероватый оттенок.
• 15-30% - развивается цианоз, кровь становится шоколадно-коричневого цвета.
• 30-50% - появляется слабость, головная боль, тахикардия, одышка при физической нагрузке, головокружение, возникают обмороки.
• 50-70% - возникает аритмия, учащенное дыхание, судороги; развивается метаболический ацидоз; отмечаются признаки угнетения ЦНС, возможна кома.
• 70% - выраженная гипоксия, летальный исход.
Ассоциированные симптомы: Головная боль. Одышка. Пальцы - барабанные палочки. Понос (диарея). Судороги. Судороги в ногах.
В зависимости от уровня фракции MtHb, выраженность проявлений врожденной и приобретенной метгемоглобинемии может значительно варьировать.
При концентрации MtHb в крови:
•.
• 3-15% - кожные покровы приобретают сероватый оттенок.
• 15-30% - развивается цианоз, кровь становится шоколадно-коричневого цвета.
• 30-50% - появляется слабость, головная боль, тахикардия, одышка при физической нагрузке, головокружение, возникают обмороки.
• 50-70% - возникает аритмия, учащенное дыхание, судороги; развивается метаболический ацидоз; отмечаются признаки угнетения ЦНС, возможна кома.
• 70% - выраженная гипоксия, летальный исход.
Ассоциированные симптомы: Головная боль. Одышка. Пальцы - барабанные палочки. Понос (диарея). Судороги. Судороги в ногах.
Диагностика
Важным диагностическим признаком метгемоглобинемии служит темно-коричный цвет крови, которая, будучи помещенной в пробирку или на фильтровальную бумагу, не изменяет свой цвет на красный. При положительной пробе проводится спектроскопия, определение концентрации MtHb, активности НАД-зависимой метгемоглобинредуктазы, электрофорез гемоглобина.
В общем анализе крови может присутствовать компенсаторный эритроцитоз, увеличение Hb, ретикулоцитоз, уменьшение СОЭ. При исследовании биохимических показателей крови определяется незначительная билирубинемия, обусловленная увеличением непрямой фракции пигмента. Для хронической метгемоглобинемии типично появление в эритроцитах телец Гейнца-Эрлиха.
У больных с энзимопенической или токсической метгемоглобинемией показательна терапевтическая проба с внутривенным введением метиленового синего - после инъекции цианоз быстро исчезает, а кожа и видимые слизистые приобретают розовую окраску.
При анализе причин метгемоглобинемии важно выяснить, имел ли больной контакт с токсическими веществами, принимал ли метгемоглобинобразующие лекарственные препараты. При подозрении на врожденную метгемоглобинемию изучается родословная, проводится консультация генетика, определяется тип наследования патологии крови. Наследственные метгемоглобинемии требуют дифференциации с врожденными пороками сердца синего типа, аномалиями развития легких и другими состояниями, сопровождающимися гипоксией.
В общем анализе крови может присутствовать компенсаторный эритроцитоз, увеличение Hb, ретикулоцитоз, уменьшение СОЭ. При исследовании биохимических показателей крови определяется незначительная билирубинемия, обусловленная увеличением непрямой фракции пигмента. Для хронической метгемоглобинемии типично появление в эритроцитах телец Гейнца-Эрлиха.
У больных с энзимопенической или токсической метгемоглобинемией показательна терапевтическая проба с внутривенным введением метиленового синего - после инъекции цианоз быстро исчезает, а кожа и видимые слизистые приобретают розовую окраску.
При анализе причин метгемоглобинемии важно выяснить, имел ли больной контакт с токсическими веществами, принимал ли метгемоглобинобразующие лекарственные препараты. При подозрении на врожденную метгемоглобинемию изучается родословная, проводится консультация генетика, определяется тип наследования патологии крови. Наследственные метгемоглобинемии требуют дифференциации с врожденными пороками сердца синего типа, аномалиями развития легких и другими состояниями, сопровождающимися гипоксией.
Лечение
Больные с отсутствием клинических проявлений не нуждаются в специальной терапии. При значительной концентрации MtHb в крови и развернутой симптоматике метгемоглобинемии назначается медикаментозная терапия, способствующая превращению метгемоглобина в гемоглобин. Такими восстанавливающими свойствами обладают аскорбиновая кислота и метиленовый синий. Аскорбиновая кислота назначается внутрь сначала в больших, а по мере нормализации состояния - в поддерживающих дозах. Раствор метиленовой сини вводится внутривенно. При выраженном цианозе проводится кислородная терапия. Тяжелая форма метгемоглобинемии является показанием к обменному переливанию крови.
|
|
Профилактика
Течение наследственной и лекарственной метгемоглобинемии, как правило, доброкачественное. Неблагоприятный исход возможен при тяжелых формах токсической метгемоглобинемии с высоким содержанием MtHb в эритроцитах. Пациентам с подобной патологией следует избегать контакта с метгемоглобинобразующими веществами, переохлаждений и других провоцирующих факторов. Профилактика врожденной метгемоглобинемии заключается в проведении медико-генетической консультации для выявления гетерозиготных носителей среди будущих родителей.